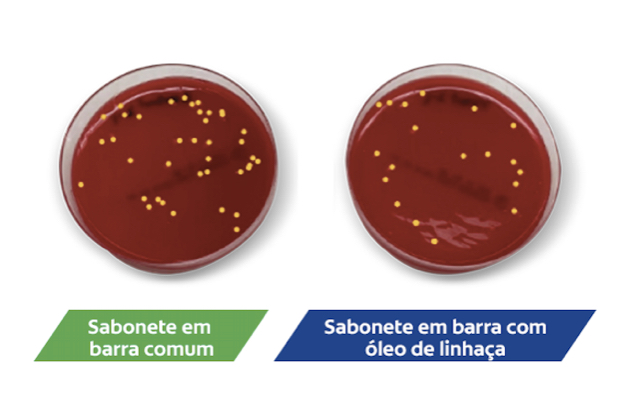
Sabonete em barra comum versus Sabonete em barra com óleo de linhaça.

Índice
O mundo está cada vez mais conectado e, com isso, aumentou o risco de presença de bactérias. É por isso que as pessoas procuram sabonetes antibacterianos como o Protex, pois sua proteção é comprovada. Os consumidores querem produtos que protejam de forma mais natural e que sejam menos agressivos à pele.
A Protex assumiu o compromisso de atender a essas necessidades, promovendo avanços científicos na proteção da saúde da pele com soluções mais naturais.
Apresentando uma grande inovação em termos de proteção da saúde da pele, a nova geração de sabonetes Protex Óleo de Linhaça oferece a mesma proteção ao consumidor, eliminando 99,9% das bactérias, mas sem os produtos químicos agressivos de outros sabonetes antibacterianos. Além disso, a linhaça é um ingrediente natural que fornece uma maneira inovadora de aumentar as defesas naturais da pele, ajudando a combater as bactérias.
O novo Protex agora tem óleo de linhaça para garantir proteção natural ao consumidor.
Como a pele serve de proteção contra bactérias?
A pele humana é uma barreira física que pode impedir a entrada de patógenos no corpo. Além disso, a pele tem sua própria defesa natural: proteínas ou peptídeos antimicrobianos (PAMs). Os PAMs fazem parte da imunidade antimicrobiana natural da pele, agindo como uma barreira protetora contra bactérias, vírus e fungos.
Os PAMs são produzidos por queratinócitos, células infiltrantes do sistema imunológico e organismos comensais da pele e a protegem como se fossem um antibiótico. Em outras palavras, os PAMs são a arma da pele para combater os patógenos.